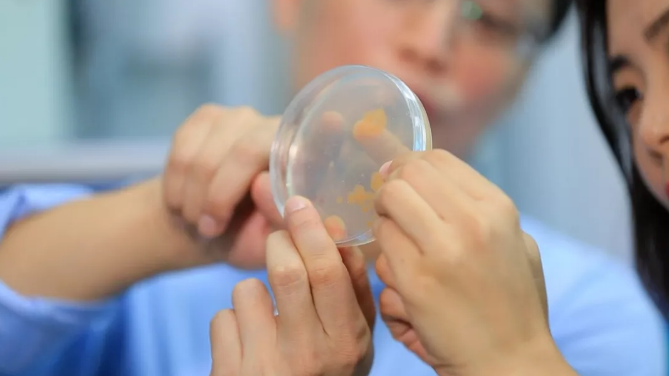
image.png

“蛟龍”號母船向陽紅

奇特的深海生物
今天,雖然我們已經可以登上月球,但是我們卻對占地球面積一半以上的深海,知之甚少。

科學家陶春輝乘坐蛟龍號考察海底黑煙囪

180度的液氮罐保存深海微生物
據科學家的估計,就是把人類已經用掉的和還沒有開發的資源加在一起,也趕不上海洋資源的一半。

“蛟龍”號深海取樣

中國是現在世界上擁有深海礦區種類最多、數量最大的國家
在世界各國爭相發展深海技術、開發海底資源的國際背景下,短短30年的時間,中國的大洋科考工作從零開始,一躍成為世界上擁有深海礦區種類最全、數量最多的國家。
本周《走遍中國》欄目
將為你奉上系列片
《走向大洋》
系列片《走向大洋》分為
《蛟龍探?!?、《深海寶藏》
《深海精靈》、《海底來客》
四集內容分別表現
以“蛟龍”號為代表的
中國深海裝備體系
中國在深海礦產勘探與開發方面
取得的驕人戰績
中國在深海生物和微生物方面的
研究成果以及取得的進展
系列片以多元化的視角
追求大敘事和小故事的平衡統一
展現中國在深海大洋方面取得成就的同時
以一個個人物故事讓你感受到
眾多成就背后無數人的艱辛付出
~精彩內容先睹為快~
蛟龍探海
中國載人潛水器“蛟龍”號是國家高技術研究發展計劃重大專項成果。在過去15年里,蛟龍號從一次次挑戰深度,創下最大下潛深度達到7062米世界作業型潛水器的最大下潛深度記錄,到連續5年進行試驗性應用,執行任務152次,采集的生物、礦物樣品都相當于中國大洋科考20年采樣的總和。
“蛟龍”號的成功,標志著中國海底載人科學研究和資源勘探能力達到國際領先水平,也標志著中國人的深海調查范圍可覆蓋全球海洋區域的99.8%。
本集節目,我們將聚焦“蛟龍”號這些奇跡背后的試驗總指揮、工程師、潛航員,通過他們講述伴隨蛟龍號一路走來不為人知的故事,回顧中國載人潛水器研發和海上試驗階段的艱辛歷程......

“蛟龍”準備入海

“蛟龍”號機械手模擬訓練

慶祝7000米級海試成功
深海寶藏
海洋占地球面積的71%!海洋地域遼闊,神秘深邃的黑暗海底隱藏著無窮的寶藏,等待人類去不斷探索。
本集節目,我們將會帶觀眾認識深海之中的錳結核、富鈷結殼、硫化物,以及被譽為“工業的維生素”稀土,了解這些深海中的寶藏對人類的重要性,以及一代代礦物學家們如何將畢生的心血都投入到這些深海資源的勘察、科考研究之中,為中國從國際海底資源調查研究的參與者,逐步變為主導者而貢獻自己的力量。

富鈷結殼科學家馬維林

科學家石學法即將與弟弟一起開啟新的科考航程

中國大洋樣品館副館長卜文瑞向我們展示藏品
深海精靈
隨著中國深海裝備的突飛猛進,每次的中國大洋科考船都能滿載而歸。原本棲息在幾千米深海的生物不再那么遙不可及,曾經令中國的海洋生物學家們夢寐以求的珍貴深海生物樣本,如今變得唾手可得。中國海洋生物研究正蓬勃發展。
本集節目,我們將和生物學家一起登上凱旋的中國大洋科考船,看看他們這次收獲了怎樣的深海生物樣本。帶你游歷神奇的海底世界,尋找生活在海綿體里的儷蝦,以及在海底黑煙囪口370度高溫熱液旁生存的盲蝦,了解中國在深海生物和深海微生物研究領域取得的成就,以及背后的故事。

“蛟龍”號采集到的深海生物維嘉擬儷蝦

與深海微生物共生的盲蝦

海洋生物學家邵宗澤講解奇特的盲蝦
海底來客
水深3000米的海底,低溫、無光、高壓......在這個極端環境中,本應是生命的禁區,然而事實卻并非如此。這里不僅生活著看上去千奇百怪的新物種,大量肉眼無法看見的深海微生物,更是本領高強,甚至將會在眾多領域改變人類的生活。
本集節目,我們將會跟隨邵宗澤在海灘石油降解試驗中感受海底微生物的威力;在實驗室里認識正在為利用海底微生物抑制腫瘤細胞生長而努力的陳建明;還會來到福建的茶園和荔枝樹下,跟隨曾潤穎看看從海底微生物中提取出的寡糖,對茶葉和水果有怎樣的神奇作用......
從深海中找到的分解龍須菜的太平洋紅色桿菌

海洋微生物學家邵宗澤正在培養可以降解石油的深海微生物

石油降解菌降解石油的效果顯著